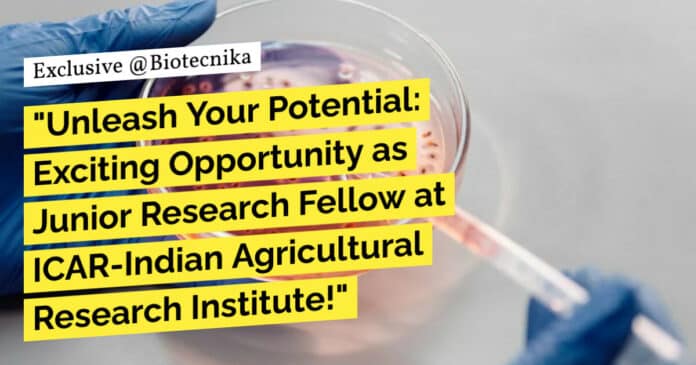

IARI JRF Job Opening For Life Sciences, Mol Bio – Apply Now
Division Plant Pathology
ICAR-Indian Agricultural Research Institute
New Delhi-110 012
F. No. 41-190/23-24/24-841
Dated: 16/05/2024
ONLINE INTERVIEW FOR JRF
Applications are invited from eligible candidates for an ONLINE INTERVIEW for recruitment of one Junior Research Fellow (JRF) in a SERB funded project on “Decoding the molecular mechanisms of a pathogenicity-related transcriptional regulator Fow2 of Fusarium oxysporum in vascular wilt of tomato” purely on contractual basis at the Division of Plant Pathology, ICAR-Indian Agricultural Research Institute, New Delhi-12.
Eligible candidates are requested to send their application in the enclosed proforma as given below and a scanned copy of self-attested original documents through email ([email protected]) latest by 05th June 2024, 5:30 PM. After screening the application, ONLY the shortlisted candidates will be called to appear for an online interview. Original documents will be verified at the time of appointment. If any candidate is found to have submitted false claims at a later stage, their candidature will be summarily rejected.
Name of the post: Junior Research Fellow (JRF)
No. of Post: One
Emolument (Fixed per month): Rs. 31,000+24% HRA per month for 1st and 2nd yr. and 35,000+24% HRA per month for 3rd-year
Qualifications:
- Essential [vide SERB OM No. SB/S9/Z06/2019 dt 23.04.2019] Post Graduate Degree in Biotechnology/Molecular Biology/Biochemistry/Plant Biology/any branch of Life Sciences and possess any one of the following: a. National Eligibility Test certificate of CSIR-UGC NET or ASRB-NET including lectureship (Assistant Professorship) and/or GATE. b. The selection process through National level examinations conducted by Central Government Departments and their Agencies and Institutions such as DST, DBT, DAE, DOS, DRDO, MHRD, ICAR, ICMR, IIT, IISC, IISER etc., during their graduation or post-graduation.
- Desirable Research experience in molecular biological techniques and works related to proteomics and bioinformatics as evidenced through publications.
Terms and Conditions:
- The above position is purely temporary and will be filled on a contractual basis. The post is co-terminus with the project and will be offered initially for one year or until the termination of the project, whichever is earlier. It is further extendable based on satisfactory performance for the remaining project period.
- The candidate age should be a maximum of 35 years, with an age relaxation of 5 years for SC/ST/Women & 3 years for OBC, applicable as per Govt. of India/ICAR Rules.
- The interview for shortlisted candidates will be held online, the details of which will be communicated to them by email. To check their eligibility, the candidates have to submit their the duly filled-in application form (as per the format annexed), along with scanned copies of a) date of birth certificate b) original or provisional certificates and mark sheets from matriculation onwards c) NET/equivalent certificate d) proof of experience e) publications and f) no objection certificate from the employer/university, in case they are in employment elsewhere. Upon joining, the selected candidate must produce all the original documents and medical certificates.
- Concealing of facts or canvassing in any form shall lead to disqualification or termination of such candidates.
- Selected candidates will not be entitled to claim for regular appointments/absorption either in this institute or in ICAR. Non‐maintenance of discipline and failure to perform the assigned duties will make the candidate liable for termination during the appointment period as per ICAR rules.
- Only candidates with essential qualifications will be considered for the online interview. All eligible candidates need to ensure good internet connectivity to attend the interview.
- The competent authority’s decision will be final and binding in all respects.
Download the application format here
Keywords: ICAR-Indian Agricultural Research Institute, Junior Research Fellow, Plant Pathology, New Delhi, Biotechnology, Molecular Biology, Biochemistry, Life Sciences. IARI JRF Job Opening For Life Sciences, Mol Bio – Apply Now. Please ensure you are subscribed to the Biotecnika Times Newsletter and our YouTube channel to be notified of the latest industry news. Follow us on social media like Twitter, Telegram, Facebook